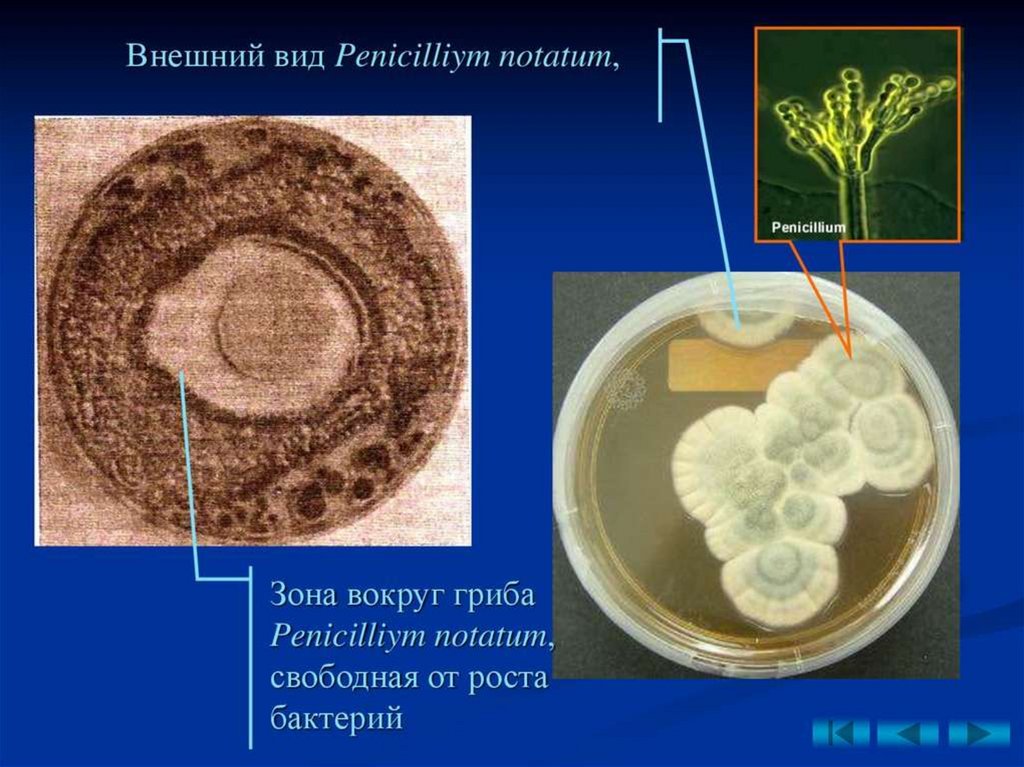

Похожие презентации:
Лекция 1: Предмет, история развития биотехнологии. Биообъекты, используемые в биотехнологии
1. ЛЕКЦИЯ 1. Тема: Предмет, история развития биотехнологии. Биообъекты, используемые в биотехнологии
Дисциплина: Объекты биотехнологии и ихпромышленное применение
1
2. РЕКОМЕНДУЕМАЯ ЛИТЕРАТУРА
1. Турпанова Р.М., Арыстанова Ш.Е. и др. Объекты биотехнологии, 2016 г.
2. Е.А. Живухина, Е.А. Калашникова, Н.В. Загоскина, Л.В Назаренко
Биотехнология. В 2 частях. Учебник и практикум для академического
бакалавриата. Под ред. Н.В. 2017.
3. Егорова, С. М. Клунова, Е. А. Живухина. Основы биотехнологии : учебное
пособие для вузов / Т. А..- М. : Академия , 2003 .- 208 с
4. Коростелева Н.И. Биотехнология: учебное пособие / Н.И. Коростелева, Т.В.
Громова, И.Г. Жукова. Барнаул: Изд-во АГАУ, 2006. 127 с.
5. Сазыкин Ю.О., Орехов С.Н., Чакалева И.И. Биотехнология.
Издательство: Academia. Серия: Высшее профессиональное образование.
2008. 256с.
6. Елинов Н.П. Основы биотехнологии/ Н.П. Елинов.– СПБ.: Наука 1995.
7. Биотехнология. В 8 кн. под ред. Н.С. Егорова, В.Д. Самуилова. - М.:
Высшая школа. 1987-1988 гг.
8. Шлегель Г. Общая микробиология. -М.: Мир. 1987.
9. Глик Б., Пастернак Дж. Молекулярная биотехнология. Принципы и
применение. – М.: Мир, 2000.
10. Бирюков В.В. Основы промышленной биотехнологии. Учеб пособие для
вузов. – М.: Колосс, 2004.
2
3.
34. План лекции
1. Предмет биотехнологии. Задачи. Методы.2. История развития биотехнологии.
3. Объекты биотехнологии.
4
5.
Что такое биотехнологии?Само слово произошло от греческих
bios — жизнь, techne — искусство,
мастерство и logos — учение.
Биотехнология – это использование живых
объектов и биологических процессов в
производстве.
6.
метаболизми биологические
возможности которых обеспечивают
выработку специфических веществ.
7.
• Биотехнология – это любые технологии, вкоторых применяются биологические
системы, живые организмы или
их
производные для создания или изменения
конечного продукта (словарь ФАО продовольственная и с\х организация ООН).
• Согласно этому определению человек
занимается
биотехнологией
уже
несколько тысячелетий.
8.
В 1984 г. Европейской Федерацией Биотехнологовдано такое определение: «Биотехнология – это
интегральное
использование
биохимии,
микробиологии и инженерных наук в целях
промышленной
реализации
способностей
микроорганизмов, культур клеток и их частей».
В 1983 г. в Братиславе на биотехнологическом
Конгрессе было принято следующее определение:
«Биотехнология – это наука, разрабатывающая
основы крупнотоннажной реализации процессов
получения с помощью катализаторов различных
продуктов и защита окружающей среды».
9.
В литературе имеется множество определений биотехнологии:1. Биотехнология – наука об использовании биологических
процессов в технике и промышленном производстве.
2.
Биотехнология
–
промышленное
использование
биологических процессов на основе микроорганизмов,
культуры клеток и тканей, а также отдельных структур и
компонентов клеток животных и растений с заданными
свойствами.
3. В современном понимании биотехнология - это наука о
технологиях создания и использования биологических
объектов, способствующих интенсификации производства или
получению новых видов продуктов различного назначения на
основе методов клеточной и генетической инженерии.
10.
Биотехнология — междисциплинарная область возниклана стыке биологических, химических и технических наук,
как: микробиология, биохимия, молекулярная биология,
генетика, неорганическая органическая, аналитическая химия,
а также включает процессы и аппараты химической и
пищевой промышленности.
11.
В основные задачи биотехнологии входит создание и широкоеосвоение:
1) новых биологически активных веществ (БАВ) и лекарственных
препаратов для медицины (инсулина, гормонов и др.), позволяющих
осуществить раннюю диагностику и лечение тяжелых заболеваний;
2) микробиологических средств защиты растений от болезней и
вредителей, бактериальных удобрений и регуляторов роста культур;
новых высокопродуктивных и устойчивых к неблагоприятным
факторам внешней среды сортов и гибридов;
3) ценных кормовых добавок и БАВ для повышения продуктивности
животноводства; новых методов биоинженерии для эффективной
профилактики, диагностики и терапии основных болезней с/х
животных;
4) новых технологий получения ценных продуктов для
использования в пищевой, химической, микробиологической и
других отраслях промышленности;
5) технологий глубокой и эффективной переработки с/х,
промышленных и бытовых отходов, использования сточных вод для
производства биогаза и высококачественных удобрений.
12.
Целенаправленноеполучение
ценных
для
народного хозяйства и человека
продуктов
Биотехнологии
за счет биохимической
деятельности
микроорганизмов
- культуры бактерий
изолированных клеток
- клеток животных
- клеток растений
компонентов клеток.
13.
Биотехнологияиспользует:
культуры
бактерий,
грибов, дрожжей
культуры
животных
клеток
культуры
растений
клеток
метаболизм
и
биологические
возможности
которых
обеспечивают
выработку
специфических
веществ.
14.
• Термин«биотехнология»
впервые был введен в 1917 г.
венгерским инженером Карлом
Эреки для описания процесса
крупномасштабного
выращивания
свиней
с
использованием в качестве корма
сахарной свеклы.
• Эреки определил биотехнологию,
как "все виды работ, при
которых те или иные продукты
производятся из сырья при
помощи живых организмов".
Karl Ereky (1878 1952)
14
15.
Он предложил процесс крупномасштабного промышленноговыращивания свиней с использованием в качестве корма
сахарной свеклы. При этом Эрике рассматривал превращение
сырья (свеклы) в целевой продукт, в данном случае свинину
как ряд биотехнологических этапов.
Однако это совершенно точное
определение
не
получило
широкого распространения.
16.
Первоначально термин «биотехнология» относился кдвум очень разным дисциплинам:
- промышленная ферментация;-эргономика.
Такой двойственности пришел конец в 1961 г., когда шведский
микробиолог Карл Гёрен Хеден порекомендовал изменить
название научного журнала «Журнал микробиологической и
биохимической
инженерии
и
технологии»),
специализирующегося на публикации работ по прикладной
микробиологии
и
промышленной
ферментации,
на
«Биотехнология и биоинженерия». С этого момента
биотехнология оказалась четко и необратимо связана с
исследованиями в области «промышленного производства
товаров и услуг при участии живых организмов,
биологических систем и процессов» и встала на прочный
фундамент микробиологии, биохимии и химической
инженерии.
16
17.
1961 г.термин
«БИОТЕХНОЛОГИЯ»
внедрен в научный
обиход
Выход журнала
«Биотехнология
и биоинженерия»
17
18. 2. Основные этапы развития биотехнологии
Человек использовал биотехнологические процессы ещемного тысяч лет назад: люди занимались пивоварением,
пекли хлеб; они придумали способы хранения и
переработки продуктов путем ферментации (производство
сыра, уксуса, соевого соуса), научились делать мыло из
жиров,
изготавливать
простейшие
лекарства
и
перерабатывать отходы.
Биотехнология формировалась и эволюционировала с
развитием человеческого общества. Ее становление
различные ученые подразделяют на несколько периодов.
• Елинов Н.П. (1995) условно выделил 4 периода:
• эмпирический,
• этиологический,
• биотехнический,
• генотехнический.
19.
Голландский ученый Е. Хаувинк (1984) выделил 5 периодов:Период
Характеристика
Допастеровекая
эра (1865)
Использование спиртового и молочнокислого брожения при
получении пива, вина, хлебопекарных и пивных дрожжей, сыра.
Получение ферментированных продуктов и уксуса.
Пастеровский
период (18661840 гт.)
Производство этанола, бутанола, ацетона, глицерина, органических
кислот, вакцин. Аэробная очистка канализационных вод.
Производство кормовых дрожжей из углеводов.
Период
антибиотиков
(1940-1960 гг.)
Производство пенициллина и других антибиотиков путем
глубинной ферментации. Культивирование растительных клеток и
получение вирусных вакцин. Микробиологическая трансформация
стероидов.
Период
управляемого
биосинтеза
(1961-1975гг.)
Производство аминокислот с помощью микробных мутантов.
Получение очищенных ферментных препаратов. Промышленное
использование иммобилизованных ферментов и клеток. Анаэробная
очистка канализационных вод и получение биогаза. Производство
бактериальных полисахаридов.
Эра новой
биотехнологии
(с 1973 г.)
Использование клеточной и генетической инженерии в целях
получения
агентов
биосинтеза.
Получение
гибридов,
продуцирующих
моноклональных
антител,
трансплантация
эмбрионов.
20.
•Археологические раскопки показывают, что ряд процессовбиотехнологии зародились в древности.
• На территории древнейших очагов в Месопотамии, Египте
сохранились остатки пекарен, пивоваренных заводов,
сооруженных 4-6 тысячелетий назад. В 3 тысячелетии до н. э.
шумеры изготовляли до двух десятков сортов пива.
• В Древней Греции и Риме широкое распространение получили
виноделие и изготовление сыра. В основе пивоварения и
виноделия лежит деятельность дрожжевых грибков,
сыроделия - молочнокислых бактерий, сычужного
фермента.
• Получение льняного волокна происходит с разрушением
пектиновых веществ микроскопическими грибами и
бактериями. Иными словами, зарождение биотехнологии тесно
связано с сельским хозяйством, переработкой растениеводческой и животноводческой продукции.
20
21. Пивоварение Хлебопечение Сыроделие
2122.
2223. 2. Послепастеровская эра (1866—1940 гг.)
• Основы сознательного управления технологическимипроцессами, в которых микроорганизмы являются
«главными работниками», были заложены Луи Пастером.
(1822 – 95 гг).
• Пастер установил микробную природу брожения,
доказал возможность жизни в бескислородных
условиях, создал научные основы вакцинопрофилактики
и др.
• В этот же период творили его выдающиеся ученики,
сотрудники и коллеги: Э. Бюхнер, Э. Дюкло, Э. Ру, Ш.Э.
Шамберлан, И.И. Мечников; Р. Кох, Д. Листер, Г. Риккетс,
Д. Ивановский и др.
23
24.
2425.
Этиологическийпериод
в
развитии
биотехнологии:
Производство этанола, бутанола, ацетона,
глицерола, органических кислот и вакцин.
Аэробная очистка канализационных вод.
Производство кормовых дрожжей из
углеводов.
В этот период было начато изготовление
прессованных пищевых дрожжей, а также
продуктов их метаболизма - ацетона,
бутанола, лимонной и молочной кислот,
во Франции приступили к созданию
биоустановок для микробиологической
очистки сточных вод.
25
26.
2627.
2728. В 1928 г. А. Флеминг открыл пенициллин как антибиотик
Организация промышленного производстваантибиотиков
В 1928 г. А. Флеминг
открыл пенициллин как
антибиотик
1881 – 1955 гг.
Penicillium notatum
29.
2930.
3031.
Х. Флори и Б. Чейн химиотерапевтическаяактивность пенициллина
Эрнст Борис Чейн
английский биохимик
1942 г. начато
массовое
производство
пенициллина
Говард Флори
английский патолог и бактериолог
32.
В 1943 г. «пенициллинкрустозин»начали
выпускать
в
СССР
промышленных
масштабах.
З. В. Ермольева
Penicillium crustosum
33.
Эра антибиотиков (1941 — 1960 гг.)Производство пенициллина и других антибиотиков
путем глубинной ферментации.
Культивирование растительных клеток и получение
вирусных вакцин.
Микробиологическая трансформация стероидов
34.
Эра управляемого биосинтеза (1961 — 1975 гг.)Производство аминокислот с помощью микробных
мутантов.
Получение чистых ферментов.
Промышленное
использование
иммобилизованных
ферментов и клеток.
Анаэробная очистка канализационных вод и получение
биогаза.
Производство бактериальных полисахаридов.
35.
Эра новой биотехнологии (после 1975 г.)Использование генной и клеточной инженерии в
целях получения агентов биосинтеза.
Получение гибридов
Моноклональных антител
Гибридов из протопластов и меристемных культур
Трансплантация эмбрионов
36.
3637.
3738.
3839.
3940.
Биотехнология -Традиционная
(классическая)
Современная
(новейшая)
клеточная
инженерия
генетическая
инженерия
41.
В традиционном смысле:как наука о методах
и технологиях производства,
хранения и переработки продукции с использованием
обычных
(нетрансгенных)
растений,
животных,
микроорганизмов в естественных и искусственных
условиях.
Новейшая биотехнология:
наука о генно-инженерных и клеточных методах,
технологиях создания
и использования генетически
трансформированных организмов (растений, животных,
микроорганизмов) в целях интенсификации производства и
получения новых видов продуктов различного назначения.
42.
ОСНОВНЫЕ НАПРАВЛЕНИЯМедицинская
С/Х
Промышленная
Экологическая
Иммунная
43.
К «белой» биотехнологии относят промышленную биотехнологию,ориентированную на производство продуктов, ранее производимых
химической промышленностью, – спирта, витаминов, аминокислот и др.
(с учетом требований сохранения ресурсов и охраны окружающей среды).
«Зеленая» биотехнология охватывает область, значимую для
сельского хозяйства. Это исследования и технологии, направленные на
создание биотехнологических методов и препаратов для борьбы с
вредителями и возбудителями болезней культурных растений и домашних
животных, создание биоудобрений, повышение продуктивности растений,
в том числе с использованием методов генетической инженерии.
«Красная» (медицинская) биотехнология – наиболее значимая
область
современной
биотехнологии.
Это
производство
биотехнологическими методами диагностикумов и лекарственных
препаратов с использованием технологий клеточной и генетической
инженерии (зеленые вакцины, генные диагностикумы, моноклональные
антитела, конструкции и продукты тканевой инженерии и др.).
44.
«Серая» биотехнология занимается разработкой технологий ипрепаратов для защиты окружающей среды; это рекультивация почв,
очистка стоков и газовоздушных выбросов, утилизация промышленных
отходов и деградация токсикантов с использованием биологических
агентов и биологических процессов.
«Синяя» биотехнология в основном ориентирована на эффективное
использование ресурсов Мирового океана. Прежде всего, это
использование морской биоты для получения пищевых, технических,
биологически активных и лекарственных веществ.
45.
КлонированиеОсновные
методы
биотехнологии
Генная
инженерия
Клеточная
инженерия
46.
Клеточная инженерияиспользует методы введения культур и
клеток и их практического
использования.
Клеточная селекция основана на
выращивании клеток (как растительных,
так и животных) вне организма на
специально
подобранных
средах
в
регулируемых условиях.
Соматическая гибридизация –
это слияние двух различных клеток в
культуре тканей.
47.
Генная(генетическая)
инженерия
–
совокупность методов, позволяющих осуществить
генетическую информацию, перенос (трансгенез)
чужеродных генов из одного организма в другой.
Генетическая инженерия (по Э.С. Пирузян) –
система экспериментальных приемов, позволяющих
конструировать лабораторным путем (в пробирке)
искусственные генетические структуры в виде так
называемых рекомбинантных или гибридных
молекул ДНК.
48.
Клонирование49. 3. Объекты биотехнологии
• Главным звеном биотехнологического процесса,определяющим всю его сущность, является
биологический объект, способный осуществлять
определенную модификацию исходного сырья и
образовывать тот или иной необходимый
продукт.
• В качестве таких объектов биотехнологии могут
выступать клетки микроорганизмов, животных
и растений, трансгенные животные и растения,
а также многокомпонентные ферментные
системы клеток и отдельные ферменты.
49
50.
Растительные иживотные
клетки
микроорганиз
мы
Биологические
объекты
биотехнологии
биологические
макромолекулы как
рибонуклеиновые
кислоты (ДНК,
РНК), белки - чаще
всего ферменты.
ДНК или РНК
необходима для
переноса
чужеродных
генов в клетки.
Части клеток:
клеточные
мембраны,
рибосомы,
митохондрии,
хлоропласты.
51.
Объекты биотехнологическихпроизводств
Грибы
(микромицеты)
Чистые
культуры
Клеточные
органеллы
Вирусы
Ферменты
кислоты
нуклеиновой
Культуры
Соматические
Мутанты микроорганизмов
Половые
51
52. Вопросы и задания для самопроверки
Вопросы и задания для самопроверки•Понятие о биотехнологии, история ее возникновения и
развития.
• Как происходило развитие биотехнологии в допастеровский
период?
•Какой ученый установил, что процессы брожения имеют
микробиологическую природу и каждый вид брожения
обусловлен своим специфическим возбудителем?
•Основные направления и задачи биотехнологии. Связь
биотехнологии с другими дисциплинами.
•Какие вопросы изучает промышленная микробиология?
•Каковы области применения биотехнологии в пищевой
промышленности?
•Перечислите основные направления биотехнологии.
52

Биология
Биология








